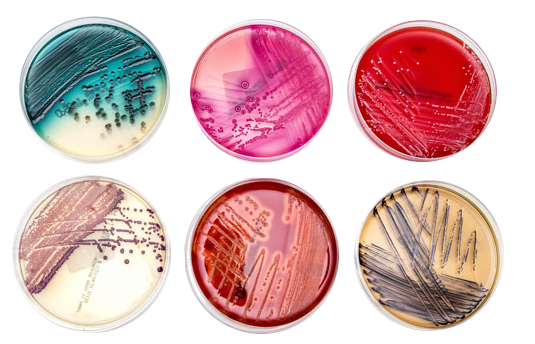

Many Platforms

We offer assistance all across the value chain for a wide variety of first and second generation waste conversion technology applications including composting, anaerobic digestion, pyrolysis, torrefaction, hydrolysis, hydro-thermal liquefaction, microbial fermentation, etc. in industries including food and beverage manufacturing, renewable chemicals, waste management, dairy and meat production, agricultural applications, water treatment, biogas and biofuels etc. We work with clients from conception through scale up and commercialization to develop solutions that convert your organic waste from a cost center to a profit center!
Real World Applications

At the core of our business model is working to fill gaps in value delivery along the waste conversion value chain. By uniquely positioning ourselves and employing a technology agnostic approach, we are able provide
practical green solutions to both waste generators from traditional industries facing challenges with managing organic waste from their manufacturing processes and the growing number of companies looking to increase the sustainability profile of their products and services. Our systems generate process ready feedstock and bio-based products for commercial and industrial applications.
Customer Advantage

Practical “green” solutions for managing commercial scale organic waste challenges Development of bio based process ready feedstock and products for commercial and industrial applications looking to reduce their carbon footprint in a cost effective manner.
Modern Tools
We work with clients to identify the underlying metabolomics involved in production of the desired molecule(s). We use the resulting information to mine organic waste sources and identify substrates (nutrients, enzyme co-factors, additives, etc.) that improve product biosynthesis.
Green Chemistry

Using green chemistry design principles, we develop sustainable pre-treatment techniques to convert organic materials into process ready feedstock with uniform composition and consistency that maintains process reliability. Our process development strategy emphasizes the use of waste derived raw materials, maximizing atom efficiency, and using renewable solvents and catalysts to improve process chemistry. We also develop custom formulations to fit individual strains or processes. Our customers can rest assured we have their back once they are ready to scale up operations.
Value At Lower Cost

Research has shown that raw materials as a percentage of COGS is higher for industrial biotech than biopharma. The introduction of recycled materials into a process can significantly reduce COGS at commercial scale while creating an added value to the biomanufacturing process by making it a bona fide waste-to-value added platform. Often times manufacturing cost can be a key decision driver when analyzing the viability of new bio-manufacturing technologies.
.








© 2026 Chloronova